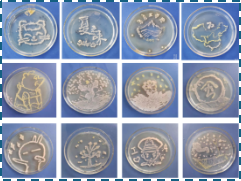

食品微生物学课程是面向食品科学与工程相关专业大学二年级学生开设的一门专业类基础课程,2024年该课程获评山东省线上线下混合式一流本科课程。课程学习内容主要包括食品微生物的形态、结构、类群、鉴定,食品微生物的生命活动规律、新陈代谢、诱变育种与遗传工程及免疫学技术。通过课堂讲授、实践项目等教学环节,使学生掌握食品微生物学研究与应用中的相关原理和技术,掌握食品微生物的分离、培养、鉴定等方法,能够分析食品工程实例中微生物对食品生产过程所起的作用及机理,能够设计满足特定食品工程需求的微生物筛选、发酵或检测试验方法,初步具备食品微生物相关项目设计能力和创新素质。该课程特色如下:
1.紧贴行业前沿的课程内容
课程紧跟食品行业发展前沿,课程内容中增设“细菌、真菌、病毒与食品实践”、“微生物与食品腐败”、“微生物与发酵食品”“食品微生物快速检验技术”等贴合行业需求的章节,结合案例教学及项目实践,启发学生利用理论知识分析现实问题,培养学生对食品微生物学理论与技术的综合应用能力。
2.信息化及立体化的教学手段
依托学习通和虚拟仿真平台,采用BOPPPS教学法、案例教学法、课内竞赛等混合式教学方法,帮助学生系统掌握知识,提高分析解决问题能力及思辨能力,提升教学效率与效果。


3.人性化及个性化的教学引导过程
开发课程各章节自主学习任务单资源,并在课前加以推送,加强对学生线上学习的引导,帮助学生在短时间内顺利完成课前线上自学环节。通过推送拓展阅读资料,引导学生开展个性化学习,提高学习的深度与广度。
4.科学合理的教学评价方式
注重过程性考核,增加随堂测验次数。采用课内竞赛和分组项目竞技方式,培养学生创新思维和团队协作能力。推动小组互评、组内互评、教师评价与生生互评等评价方式的协同应用。将小组讨论、思维导图、课堂演讲、课内竞赛、项目实践等环节纳入考核范围,创设全面立体的综合评价体系。